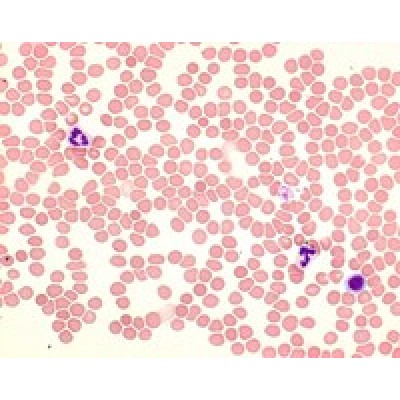
Los Angeles

GIEMSA (SOLUÇÃO) EOSINA AZUL DE METILENO MERCK - 500ML
Modelo: 1092040500
-
R$166,10
ou até 3x de R$55,37 sem juros
Economize 5% no PIX: R$157,80
ou 3.5% no boleto: R$160,29
Descrição
109204 Azur-eosina-azul de metileno em solução segundo Giemsa
para microscopia
Armazenagem Armazenar de +15°C a +25°C.
Dados físico-químicos
Temperatura de Ignição 455 °C
Solubilidade em água (20 °C) solúvel
Densidade 0.99 g/cm3 (20 °C)
Valor de pH 6.1 - 7.0 (H2O, 20 °C) (Não diluído)
Ponto de Ebulição >65 °C
Limite de explosão 5.5 - 36.5 %(V) Metanol
Ponto de inflamação 18 °C
para microscopia
Armazenagem Armazenar de +15°C a +25°C.
Dados físico-químicos
Temperatura de Ignição 455 °C
Solubilidade em água (20 °C) solúvel
Densidade 0.99 g/cm3 (20 °C)
Valor de pH 6.1 - 7.0 (H2O, 20 °C) (Não diluído)
Ponto de Ebulição >65 °C
Limite de explosão 5.5 - 36.5 %(V) Metanol
Ponto de inflamação 18 °C